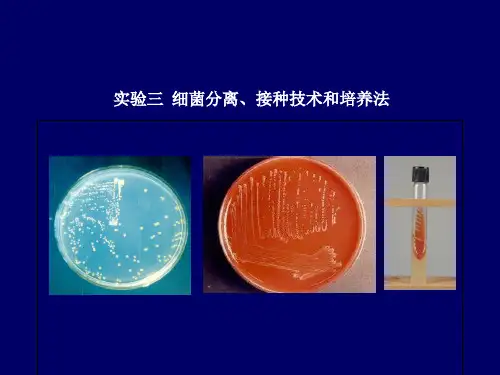

接种、分离纯化和培养技术
- 格式:doc
- 大小:126.00 KB
- 文档页数:5

实验五微生物的分离、接种及培养法一目的要求1.掌握倒平板的方法、划线分离法、稀释平板分离法和菌落(活菌)计数法。
2.熟练掌握微生物的接种技术,学会微生物的一般培养方法和无菌操作技术。
二实验原理从混杂的微生物群体中获得只含有某一种或某一株微生物的过程称为微生物的分离与纯化。
常用的分离方法有: 1) 平板划线分离法;2)稀释平板分离法。
在食品发酵工业中,通过微生物的分离、纯化,选育优良的微生物菌种,以提高产品的质量和产量;在食品卫生管理方面,需要进行微生物检测,必须将微生物单一分离出来,加以鉴别和研究。
土壤是微生物生活的大本营,它所含微生物无论是数量还是种类都是极其丰富的。
因此土壤是微生物多样性的重要场所,可以从中分离、纯化得到许多有价值的菌株。
微生物的分离和接种是微生物学中重要的技术之一,需要严格的无菌操作,否则使得微生物实验毫无意义。
三实验材料1.菌种:葡萄球菌、枯草杆菌、大肠杆菌、酵母菌、毛霉、曲霉、青霉等含菌样品。
2.培养基:肉汤蛋白胨培养基(斜面、平板)、肉汤蛋白胨液体培养基、蔡氏琼脂培养基(斜面、平板)。
3.土壤(自带)或其他物品;无菌水,无菌培养基,无菌吸管,无菌三角瓶等。
四实验内容与步骤(一)微生物的分离技术1. 平板划线分离法借助划线使混杂的微生物在平板的表面分散开,以获得单个菌落,从而达到分离的目的。
具体方法如下:倒制平板→制备含菌样品稀释液→划线→倒置适温培养→观察记录(1)倒制平板:将固体培养基熔化→冷却至 50-55℃→注入培养皿内 15ml(无菌操作)→旋匀→静置凝固→即成平板→在皿盖边贴标。
(2)含菌样液制备:样品少许(1-10g),加入盛有无菌水的试管内,摇匀,制成菌悬液即可,能直接划线的样品(如体液、黏液、污水等),可省去这操作。
(3)划线:左手持平板,接种环经灼烧灭菌后,以无菌操作取样,迅速将接种环伸入培养皿,轻轻划线(切勿把平板表面划破)。
然后将培养皿倒置放入恒温培养箱37℃,培养24-48 小时,观察平板上出现的现象,注意菌落的形状,并做记录。

环工综合实验细菌的分离纯化和接种实验实验报告环境科学与工程学院实验中心实验原理问答题:1.为什么湖水用10-4、10-5、10-6稀释液进行平板稀释分离而不用更高或者更低的浓度?答:因为在这三个浓度范围内能尽量使样品中的微生物分散开,使其成单个个体/细胞存在,否则一个菌落就不只是代表一个个体生长而成的,从而方便计数。
2.为什么平板培养皿要倒置放入恒温箱中进行培养?答:第一,为了防止重力对菌落的生成产生影响;第二,为了防止培养基中的水分蒸发后凝结在壁上,滴落后影响菌的生长和形态观察;第三,防止培养基干涸。
3.微生物常用接种方式有哪些?进行微生物接种应该注意哪些方面?答:⑴划线接种,涂布接种,穿刺接种,三点接种,浇混接种,液体接种,注射接种,活体接种等。
⑵接种用具及培养基等均需灭菌处理,接种过程必须在煤气灯旁进行,接种环、玻璃涂棒等器具要过火处理,把所要用到的器材和菌种培养基有序编号放置,操作时应避免已经灭菌处理的材料用具与周围的物品的接触,往培养基是划线或点菌时动作要轻以防把培养基划破等。
四、实验步骤1.制备细菌稀释液:使用5ml移液管加4.5ml无菌水放入贴有10-3、10-4、10-5、10-6标签的小试管中,用一根1ml的无菌移液管吸取10-2的湖水稀释液0.5ml放入贴有10-3标签的小试六、思考题1.氧化亚铁硫杆菌(Thiobacillusferrooxidans,T.f )为生物冶金重要菌种,属微生物中原核生物界、化能营养原核生物门、细菌纲、硫化细菌科、硫杆菌属。
广泛存在于土壤、海水、淡水、垃圾、硫磺泉和沉积硫内,尤以金属硫化矿和煤矿等酸性矿坑水(pH<4)中最为常见。
其化能自养,专性好氧,嗜酸,革兰氏阴性,,主要利用利用CO2为碳源,并吸收氮、磷等无机营养来合成自身细胞。
请思考其分离纯化的方法和步骤。
答:采取酸性矿坑水或实验室浸矿培养液作为菌液,在实验室用9K或Leathen 培养基反复分离纯化。

实验二微生物的分离、纯化和接种微生物的分离、纯化1、目的要求1.1了解微生物分离和纯化的原理1.2掌握常用的纯化分离微生物的方法2、基本原理从混杂的微生物群体中获得只含有某一种或某一株微生物的过程称为微生物的分离与纯化。
本实验采用平板分离法:该方法操作简便,普遍用于微生物的分离与纯化。
其基本原理是选择适合于待分离微生物的生长条件,如营养成分、pH值、温度和溶解氧等要求,或者加入某种抑制剂造成只利于该微生物生长,而抑制其它微生物生长的环境,从而淘汰一些不需要的微生物。
微生物在固体培养基生长形成的单个菌落可以是一个细胞繁殖而成的集合体,因此可通过挑取单菌落而获得一种纯培养。
获得单个菌落的方法可通过稀释涂布平板或平板划线等技术来完成。
而纯培养的确定除观察其菌落特征外,还要结合显微镜检测个体形态特征后才能确定,有些微生物的纯培养要经过一系列分离与纯化过程和多种特征鉴定才能得到。
本实验将在混合有几种微生物菌液中分离纯化出两种微生物来。
3、实验材料3.1培养基肉汤培养基(固体)。
3.2溶液或试剂盛4.5ml无菌水的试管,其中有一只盛有玻璃珠。
3.3仪器或其他用具无菌玻璃涂棒,无菌吸管,接种环,无菌培养皿,涂布器等。
4流程倒平板制备梯度稀释液涂布(或划线法)培养挑单菌落保存。
5、步骤5.1平板划线分离法5.1.1倒平板倒平板的方法:右手持盛培养基的试管或三角瓶置火焰旁边,用左手将试管塞或瓶塞轻轻地拔出,试管或瓶口保持对着火焰;然后左手拿培养皿并将皿盖在火焰附近打开一缝,迅速倒入培养基约15ml,加盖后轻轻摇动培养皿,使培养基均匀分布在培养皿底部,然后置于桌面上,待凝固后即成平板(教材p367图13-14)。
并用记号笔标明培养基名称、菌液编号和试验日期。
5.1.2划线在近火焰处,左手拿皿底,右手拿接种环,挑取菌悬液一环在平板上划线(教材p367图13-15)。
划线的方法很多,但无论采用哪种方法,其目的都是通过划线将样品在平板上进行稀释,使之形成单个菌落。

微生物的分离、接种和培养技术一、实验的目的和内容目的:掌握微生物接种和分离纯化技术,掌握无菌操作技术。
内容:用平板划线法分离微生物;学习斜面接种及穿刺接种等无菌操作技术。
二、基本原理在自然界中,各种微生物是在互为依赖的关系下共同生活的。
因此,为了取出特定的微生物进行纯培养,必须从中把他们分离出来。
微生物接种技术是进行微生物实验和相关研究的基本操作技能。
无菌操作是微生物接种技术的关键。
接种是将微生物或微生物悬液引入新鲜培养基的过程。
由于实验目的、培养基种类及实验器皿等不同,所用接种方法不尽相同。
斜面接种、液体接种、固体接种和穿刺接种操作均以获得生长良好的纯种微生物为目的。
分离培养微生物时,要考虑微生物对外界的物理、化学等因素的影响。
即选择该类微生物最适合的培养基和培养条件。
在分离、接种、培养过程中,均需严格的无菌操作,防止杂菌侵入,所用的器具必须经过灭菌,接种工具无论使用前后都要经过灭菌,且在无菌室或无菌箱中进行。
三、材料及器材(一)菌种:大肠杆菌、枯草杆菌,金黄色葡萄球菌,酵母菌。
(二)培养基:肉汤培养基试管斜面,肉汤半固体培养基,肉汤固体培养基试管斜面,肉汤固体培养基平板,查氏培养基试管斜面,查氏培养基平板。
易(三)仪器及其他工具:接种环,接种针,接种钩,镊子,酒精灯,火柴,酒精棉,试管架,标签纸,恒温培养箱等。
四、方法与步骤(一)接种。
1、试管菌种转接:试管细菌菌种转接主要用于菌种的活化、分离、纯化。
(1)将菌种试管与待接种的试管培养基依次排列,挟于左手的拇指与其他四指之间,用右手的无名指与小指和手掌边拔出棉塞并挟住。
(2)置试管口于酒精火焰附近。
(3)将接种工具垂直插入酒精火焰中烧红,再横过火焰3次,然后再放入有菌试管中,在管壁上停留片刻待其冷却。
(4)取少许菌种置于另一支试管中,按一定的接种方式把菌种接种到新的培养基上。
(5)取出接种工具,试管口和棉塞进行火焰灭菌。
(6)重新塞上棉塞。
(7)烧死接种工具上的残余菌,把试管和接种工具放回原处。

菌种的制备实验报告本实验的目的是制备一种菌种,用于后续的微生物实验或应用。
实验原理:菌种的制备可以通过无菌培养的方法进行。
一般分为四个步骤:接种、分离纯化、培养和保存。
首先,需要选择目标菌种并进行接种。
接种时,必须保持无菌操作,以避免其他菌种的污染。
然后,通过分离纯化的方法将目标菌种与其他菌种进行分离。
分离纯化的方法常见的有均匀涂布法、垫洗法等。
分离纯化后,选择经过分离纯化的菌落,进行培养。
培养时,需要选择适宜的培养基,控制适宜的培养条件,以保证菌种的繁殖。
最后,需要制备适当的保存条件,以保存制备好的菌种,以备后续的使用。
实验材料:1. 目标菌种2. 培养基及培养基成分3. 灭菌器材(如培养皿、试管、移液器、无菌棉签等)4. 培养箱5. 培养基制备器材(如天平、游标瓶、分注器等)实验步骤:1. 准备培养基:根据目标菌种的需求,选择适宜的培养基。
准备培养基的原材料,并按照预定比例称量和配制。
将培养基倒入培养皿或试管中,用高压蒸汽灭菌器对培养基进行灭菌处理。
2. 环境无菌准备:在实验台面上放置无菌工作台或将实验台用火酒擦拭消毒。
同时,准备所需的无菌操作器具,如试管、培养皿、无菌吸管等。
3. 目标菌种接种:通过无菌技术,将目标菌种接种到培养基上。
一般情况下,可以用火酒灯对吸管、移液器等工具进行高温灭菌处理。
然后,取少量的目标菌种,将其接种到培养基上。
使用无菌吸管或无菌棉签等工具,将菌种均匀涂布到培养基上。
4. 培养:将涂抹好菌种的培养皿放入培养箱中,控制适宜的培养条件,如温度、湿度、光照等。
根据目标菌种的需要,培养时间一般在24-48小时内。
5. 分离纯化:根据培养结果,选择纯净的菌落进行分离。
使用无菌吸管或无菌棉签将菌落分离到其他培养皿中,最后进行单菌落的纯化培养。
6. 保存:将分离纯化后的菌种保存在适宜的保存条件下。
常见的保存方法有冷冻保存和冷冻干燥保存。
在保存前,可以使用无菌琼脂地洞验证保存的菌种是否纯净。

微生物的接种与分离纯化技术及培养方法
(一)接种:将微生物接到适于它生长繁殖的人工培养基上或活的生物体内的过程叫做接种。
1、接种工具和方法
1.接种针2.接种环3.接种钩4.5.玻璃涂棒6.接种圈7.接种锄8.小解剖刀
2、常用的接种方法
•1)划线接种2)点植接种3)穿刺接种4)倾注接种
•5)涂布接种6)液体接种7)注射接种8)活体接种
(二)、分离纯化
1 稀释倾注平板法:
1、先稀释样品,加入平板
2、倒平板时注意培养基温度
3、混合均匀
3、平板划线法:.斜线法 2.曲线法 3.方格法 4.放射法 5.
四格法
平板划线法:1、倒平板,标记培养基名称,编号和实验日期。
2、划线方法
微生物的培养方法
(一)一般培养法(需氧培养)
•培养温度:25~37℃;接种后平板、试管、三角瓶,置于恒温培养箱
(二)、厌氧培养方法
1、简易的厌氧培养法:
•(1)庖肉培养法
•(2)铁丝圈厌氧培养法
•(3)焦性没食子酸法
2、厌氧罐法
3、厌氧手套箱法
A、厌氧缸法:厌氧缸是普通的干燥缸,用物理化学的方法使缸内造成厌氧环境,从而将厌氧菌培养出来。
•接种好标本的平板或液体培养基试管,可放入厌氧缸内
培养。
B、厌氧罐法:装入待培养的对象,然后密闭罐盖,接着可采用抽真空→灌氮→抽真空→灌氮→抽真空→灌混合气(N2∶CO2∶H2=80∶10∶10,V/V)。
(三)二氧化碳培养法
•1、烛缸法2、二氧化碳置換法
•3、化学法:每一升用重碳酸钠0.4克与浓盐酸0.35亳升加入
•4、二氧化碳培养箱法。

环工综合实验细菌得分离纯化与接种实验实验报告环境科学与工程学院实验中心实验原理问答题:1、为什么湖水用10-4、10-5、10-6稀释液进行平板稀释分离而不用更高或者更低得浓度?答:因为在这三个浓度范围内能尽量使样品中得微生物分散开,使其成单个个体/细胞存在,否则一个菌落就不只就是代表一个个体生长而成得,从而方便计数。
2、为什么平板培养皿要倒置放入恒温箱中进行培养?答:第一,为了防止重力对菌落得生成产生影响;第二,为了防止培养基中得水分蒸发后凝结在壁上,滴落后影响菌得生长与形态观察;第三,防止培养基干涸。
3、微生物常用接种方式有哪些?进行微生物接种应该注意哪些方面?答:⑴划线接种,涂布接种,穿刺接种,三点接种,浇混接种,液体接种,注射接种,活体接种等。
⑵接种用具及培养基等均需灭菌处理,接种过程必须在煤气灯旁进行,接种环、玻璃涂棒等器具要过火处理,把所要用到得器材与菌种培养基有序编号放置,操作时应避免已经灭菌处理得材料用具与周围得物品得接触,往培养基就是划线或点菌时动作要轻以防把培养基划破等。
四、实验步骤1、制备细菌稀释液:ﻭ使用5ml移液管加4、5ml无菌水放入贴有10—3、10—4、10-5、10-6标签得小试管中,用一根1ml得无菌移液管吸取10-2得湖水稀释液0、5ml放入贴有10-3标签得小试管中,1ml得无菌移液管吸洗三次以混匀。
然后用另外一支1ml得无菌移液管从贴有10-3标签得小试管中吸取10-3得湖水稀释液0、5ml放入贴10—4标签得小试管中,吸洗三次以混匀。
同法依次连续稀释六、思考题1、氧化亚铁硫杆菌( Thiobacillusferrooxidans,T、f )为生物冶金重要菌种,属微生物中原核生物界、化能营养原核生物门、细菌纲、硫化细菌科、硫杆菌属。
广泛存在于土壤、海水、淡水、垃圾、硫磺泉与沉积硫内,尤以金属硫化矿与煤矿等酸性矿坑水(pH<4)中最为常见。
其化能自养,专性好氧,嗜酸,革兰氏阴性,,主要利用利用CO2为碳源,并吸收氮、磷等无机营养来合成自身细胞。

微生物实验中的接种、分离和培养操作步骤微生物实验中的接种、分离和培养操作步骤一、目的要求1、掌握各种分离、接种方法。
2、掌握无菌操作基本环节。
二、实验说明微生物在自然界中呈混杂状态存在,要获得所需菌种,必需从中把它们分离出来。
在保存菌种时不慎受到到污染也需予以分纯。
微生物分离和纯化的方法很多,但基本原理却是相似的,即将待分离的样品进行一定的稀释,并使微生物的细胞(或孢子)尽量以分散状态存在,然后使其长成一个个纯种单菌落。
然而上述工作又离不开接种,即将一种微生物移到另一灭过菌的培养基上的过程。
三、实验材料1、恒温培养箱。
2、接种环、玻璃棒、吸管、酒精灯。
3、培养基(上次实验配制的)。
4、大肠杆菌、枯草杆菌、金黄色葡萄球菌、酵母菌。
四、方法步骤(一)接种的操作1、斜面接种(接金黄葡萄球菌)(1)操作前,先用75%酒精擦手,待酒精挥发后点燃酒精灯。
(2)将菌种管和斜面握在左手大姆指和其它四指之间,使斜面和有菌种的一面向上,并处于水平位置。
(3)先将菌种和斜面的棉塞旋转一下,以便接种时便于拔出。
(4)左手拿接种环(如握钢笔一样),以火焰上先将环端烧红灭菌,然后将有可能伸入试管其余部位也过火灭菌。
(5)用右手的无名指、小指和手掌将菌种管和待接斜面试管的棉花塞或试管帽同时拔出,然后让试管口缓缓过火灭菌(切勿烧过烫)。
(6)将灼烧过的接种环伸入菌种管内,接种环在试管内壁或未长菌苔的培养基上接触一下,让其充分冷却,然后轻轻刮取少许菌苔,再从菌种管内抽出接种环。
(7)迅速将沾有菌种的接种环伸入另一支待接斜面试管。
从斜面底部向上作“Z”形来回密集划线。
有时也可用接种针仅在培养基的中央拉一条线来作斜面接种,以便观察菌种的生长特点。
(7)迅速将沾有菌种的接种环伸入另一支待接斜面试管。
从斜面底部向上作“Z”形来回密集划线。
有时也可用接种针仅在培养基的中央拉一条线来作斜面接种,以便观察菌种的生长特点。
(8)接种完毕后抽出接种环灼烧管口,塞上棉塞。

细菌的分离纯化和接种实验引言细菌的分离纯化和接种实验是微生物学研究中常用的实验方法之一。
通过这个实验,我们可以将混合细菌群体中的某种特定细菌分离出来,并进行纯化和培养。
本文将介绍细菌的分离纯化和接种实验的步骤和注意事项。
材料和方法实验材料•需要分离的混合细菌样品•无菌培养基•培养皿•灭菌的培养液•灭菌的试管和移液器•灭菌的培养箱•实验台实验步骤1.准备工作–消毒实验台和所需实验用具,保证实验环境无菌。
–准备好无菌培养基和培养皿。
2.分离细菌–从混合细菌样品中取一小部分,加入无菌培养基中。
–用无菌的移液器均匀涂抹混合液在无菌培养皿上。
–将培养皿密封好,放入灭菌的培养箱中进行培养。
3.纯化细菌–经过一段时间的培养,观察培养皿中的菌落情况。
–选择一个孤立的菌落,用无菌的移液器将其转移到另一个无菌培养皿中。
–重复上述步骤,直至获得纯化的菌落。
4.培养细菌–将纯化的菌落转移到新的无菌培养基中。
–用无菌的移液器均匀涂抹细菌液在无菌培养皿上。
–将培养皿密封好,放入灭菌的培养箱中进行培养。
5.接种实验–准备好待接种的培养基和细菌培养液。
–用无菌的移液器取适量的细菌培养液,加入到待接种的培养基中。
–轻轻摇动培养基,使细菌均匀分布。
–将接种好的培养基放入培养箱中进行培养。
6.结果分析–经过一段时间的培养,观察接种后的培养基中细菌的生长情况。
–记录菌落的数量和形态特征,如颜色、形状等。
注意事项•实验过程中要保持实验环境的无菌状态,严禁对细菌样品和培养基进行交叉污染。
•实验操作要轻柔,避免对细菌造成机械损伤。
•实验结束后,要对实验用具进行正确的处理和消毒,防止细菌的传播和感染。
结论细菌的分离纯化和接种实验是微生物学研究中常用的实验方法。
通过这个实验,我们可以从混合细菌群体中分离出特定细菌,并进行纯化和培养。
这些分离纯化的细菌可以用于后续的微生物学研究和实验,为我们深入了解细菌的特性和功能提供了重要的基础。
在实验操作过程中,我们要严格遵守无菌操作的要求,保证实验的可靠性和准确性。

实验四微生物的分离、纯化和接种(一)微生物的分离、纯化1 目的1.1 了解微生物分离和纯化的原理1.2 掌握常用的分离纯化微生物的方法2 原理从混杂微生物群体中获得只含有某一种或某一株微生物的过程称为微生物分离与纯化。
平板分离法普遍用于微生物的分离与纯化。
其基本原理是选择适合于待分离微生物的生长条件,如营养成分、酸碱度、温度和氧等要求,或加入某种抑制剂造成只利于该微生物生长,而抑制其他微生物生长的环境,从而淘汰一些不需要的微生物。
微生物在固体培养基上生长形成的单个菌落,通常是由一个细胞繁殖而成的集合体。
因此可通过挑取单菌落而获得一种纯培养。
获取单个菌落的方法可通过稀释涂布平板或平板划线等技术完成。
值得指出的是,从微生物群体中经分离生长在平板上的单个菌落并不一定保证是纯培养。
因此,纯培养的确定除观察其菌落特征外,还要结合显微镜检测个体形态特征后才能确定,有些微生物的纯培养要经过一系列分离与纯化过程和多种特征鉴定才能得到。
土壤是微生物生活的大本营,它所含微生物无论是数量还是种类都是极其丰富的。
因此土壤是微生物多样性的重要场所,是发掘微生物资源的重要基地,可以从中分离、纯化得到许多有价值的菌株。
本实验将采用不同的培养基从土壤中分离不同类型的微生物。
3 材料3.1 培养基淀粉琼脂培养基(高氏I号培养基),牛肉膏蛋白胨琼脂培养基,马丁氏琼脂培养基,查氏琼脂培养基。
3.2 溶液或试剂10%酚液,盛9ml无菌水的试管,盛90ml无菌水并带有玻璃珠的三角烧瓶,4%水琼脂。
3.3 仪器或其它用具无菌玻璃涂棒,无菌吸管,接种环,无菌培养皿,链霉素和土样,显微镜,血细胞计数板、涂布器等。
4 流程倒平板→制备梯度稀释液→涂布(或划线法)→培养→挑单菌落→保存。
5 步骤5.1 稀释涂布平板法5.1.1 倒平板将牛肉膏蛋白胨琼脂培养基、高氏I号琼脂培养基、马丁氏琼脂培养基加热溶化待冷至55~60℃时,高氏I号琼脂培养基中加入10%酚数滴,马丁氏培养中加入链霉素溶液(终浓度为30μg/ml),混合均匀后分别倒平板,每种培养基倒三皿。
微生物分离纯化与接种技术微生物分离纯化与接种技术微生物学是一门研究微生物的学科,在医学、食品工业、环境保护等行业有着广泛的应用。
而微生物的研究需要用到微生物分离纯化与接种技术,这些技术可以让我们有效地获取纯净的微生物,并在实验室中控制其生长条件,从而更好地研究微生物的特性和应用价值。
按照微生物的性质,可以将微生物分为细菌、真菌和病毒三大类。
不同的微生物类型需要不同的分离纯化与接种技术。
细菌分离纯化技术是微生物学中最基础的技术,其中最常用的方法就是传统的培养基分离法。
这种方法直接将微生物置于固体培养基中,允许其在特定的温度和pH条件下生长,然后通过形态特征和生长习性的观察,将细菌区分出来。
而对于那些难以直接用固体培养基分离纯化出来的细菌,我们还可以采用流式细胞术分离法、限制性酶切片段长度多态性分析法等先进的分离技术。
真菌分离纯化技术一般采用无菌活体动物或者人工培养基的方法。
在真菌分离和鉴定时,需要根据真菌的外部形态、菌丝的生长特性和菌落的颜色等特征来进行区分和鉴定。
为了保证真菌的纯度,我们也需要通过重复传代、提取DNA序列、限制性酶切片段长度多态性分析等方法进行多角度的鉴定,以确保纯化出来的真菌种类正确。
病毒是一种极小的微生物,一般无法在常规的细胞培养中生长。
因此,分离纯化技术对于病毒的研究尤其重要。
常见的病毒分离技术有鸡胚培养、细胞培养等。
鸡胚培养可以在和病毒感染相同的生理和代谢环境下使病毒生长,而细胞培养则是让病毒通过培养基中细胞对它的反应来分离纯化。
此外,病毒也可以通过电镜、PCR等现代分析技术来进行分离纯化和鉴定。
接种技术是指将纯化出来的微生物直接加入到培养基或其他基质中,让它们在有利的环境中进行生长和加工。
接种技术对于微生物学的研究至关重要,它可以帮助我们更好地了解微生物的特性,有效地应用于医学、环境保护、食品工业以及其他相关行业。
总之,微生物分离纯化与接种技术是微生物学中的重要技术,在微生物学和相关行业中有着广泛的应用。
微生物纯种分离,培养及接种技术实验原理微生物纯种分离、培养及接种技术是微生物学中最基本的实验技术之一。
其目的是从混合的微生物菌群中分离出单一的微生物菌落,并在适宜的培养条件下进行纯化和生长,以获得纯种微生物。
一、实验器材和试剂1.灭菌针2.毛细胞计数板3.显微镜4.平板接种器、针头5.无菌匀浆棒、吸管6.细菌培养基7.消毒液二、实验步骤1. 样品处理及制备首先需要选择一份待测试的样品,包括土样、水样、空气、食品等,然后将样品采集到无菌容器中,再将其送到实验室。
在进行样品处理之前,需要先进行简单的初步处理,将样品进行稀释或者过滤,将其中的杂质和大颗粒物去除,以利于后续实验的操作。
接下来需要进行制备培养基,根据不同的微生物种类,需要选择适当的培养基进行培养。
通常情况下,我们可以使用凝胶培养基、液体培养基、甜菜汁培养基等,以满足微生物在不同环境下生长所需的营养物和成分。
2.分离纯化分离纯化是该实验的关键步骤。
将经过预处理的样品移到无菌试管中,打开试管口,加入适量的制备好的培养基,然后利用匀浆棒或吸管将混合物均匀混合。
然后利用平板接种器将混合物接种到培养基平板上,使其密切接触。
然后将接种好的平板置于恒温箱中,以利于微生物的生长和营养物质的自我繁殖。
在接种后2-7天内,不同类型的微生物将在培养基平板上生长出不同的菌落,每一种菌落都代表一种单一的微生物。
将这些菌落分离提取,并再次进行培养,就能得到单纯的微生物菌种。
3.纯种微生物菌种接种在获得单纯的微生物菌种之后,需要将其再次接种到培养基中进行培育。
将相应体积的纯种菌种接种到培养基平板上,使其能够生长繁殖。
在接种后约24小时内,微生物将在培养基中生长出许多菌落。
根据菌落的特征和形态,可以对不同的微生物进行鉴定和分类。
如果需要进行更加深入的分析,可以对微生物菌种进行进一步培养、萃取定量和测序等工作,以获取更多的相关信息。
三、实验注意事项1. 实验前需要保证实验室内部环境和仪器均为无菌状态。
实验六微生物的接种、分离和培养一、目的要求1.理解和掌握微生物接种、分离基本技术的原理与操作要领。
2.熟悉微生物接种、分离的无菌操作过程。
3.了解微生物需氧培养的方法。
4.学会观察和描述微生物的各种培养性状。
二、实验原理1. 微生物接种指将微生物纯种或含菌材料转移到另一营养基质上的过程。
根据不同的目的可采用的不同的接种方法,如平板划线法、斜面划线法、浸洗法、涂布法、倾注法、穿刺法、点植法和影印法。
2. 微生物分离指依据微生物的特征,采用各种方法从含菌样品中获得由单一个体(如单一菌体或孢子)或一段菌丝生长繁殖形成的微生物群体的过程。
常用的分离方法有:平板划线法、稀释涂布平板分离法、稀释倾注平板分离法和单细胞分离法。
平板分离法的基本原理包括两个方面:(1)选择适合于待分离微生物的生长条件,如营养、酸碱度、温度和氧等要求或加入某种抑制剂造成只利于该微生物生长,而抑制其他微生物生长的环境,从而淘汰一些不需要的微生物。
(2)微生物在固体培养基上生长形成的单个菌落可以是由一个细胞繁殖而成的集合体。
因此可通过挑取单菌落而获得一种纯培养。
值得指出的是从微生物群体中经分离生长在平板上的单个菌落并不一定保证是纯培养。
因此,纯培养的确定除观察其菌落特征外,还要结合显微镜检测个体形态特征后才能确定,有些微生物的纯培养要经过一系列的分离与纯化过程和多种特征鉴定方能得到。
3. 微生物培养指微生物被接种到营养基质后,在一定条件下生长繁殖的过程,分需氧培养法和厌氧培养法。
本实验所做的需氧培养法,是采用生化培养箱和恒温摇床进行的。
4. 微生物的培养形状培养性状是微生物在培养基上所表现的群体形态和生长情况。
平板菌落特征、斜面和液体培养特征、半固体穿刺培养特征等培养性状,是鉴定微生物的重要形态学依据。
菌落是由单个或少数细胞在固体培养基表面或里面生长繁殖所形成的眼可见的子细胞群体。
菌落形态会因菌种不同或菌种相同但所用培养基、培养温度和时间等条件不同而存在不同程度的差异。
接种、分离纯化和培养技术一、接种将微生物接到适于它生长繁殖的人工培养基上或活的生物体内的过程叫做接种。
1、接种工具和方法在实验室或工厂实践中,用得最多的接种工具是接种环、接种针。
由于接种要求或方法的不同,接种针的针尖部常做成不同的形状,有刀形、耙形等之分。
有时滴管、吸管也可作为接种工具进行液体接种。
在固体培养基表面要将菌液均匀涂布时,需要用到涂布棒。
(图3-3)图3-3接种和分离工具1.接种针 2.接种环3.接种钩4.5.玻璃涂棒6.接种圈7.接种锄8.小解剖刀常用的接种方法有以下几种:1)划线接种这是最常用的接种方法。
即在固体培养基表面作来回直线形的移动,就可达到接种的作用。
常用的接种工具有接种环,接种针等。
在斜面接种和平板划线中就常用此法。
2)三点接种在研究霉菌形态时常用此法。
此法即把少量的微生物接种在平板表面上,成等边三角形的三点,让它各自独立形成菌落后,来观察、研究它们的形态。
除三点外,也有一点或多点进行接种的。
3)穿刺接种在保藏厌氧菌种或研究微生物的动力时常采用此法。
做穿刺接种时,用的接种工具是接种针。
用的培养基一般是半固体培养基。
它的做法是:用接种针蘸取少量的菌种,沿半固体培养基中心向管底作直线穿刺,如某细菌具有鞭毛而能运动,则在穿刺线周围能够生长。
4)浇混接种该法是将待接的微生物先放入培养皿中,然后再倒入冷却至45°C左右的固体培养基,迅速轻轻摇匀,这样菌液就达到稀释的目的。
待平板凝固之后,置合适温度下培养,就可长出单个的微生物菌落。
5)涂布接种与浇混接种略有不同,就是先倒好平板,让其凝固,然后再将菌液倒入平板上面,迅速用涂布棒在表面作来回左右的涂布,让菌液均匀分布,就可长出单个的微生物的菌落。
6)液体接种从固体培养基中将菌洗下,倒入液体培养基中,或者从液体培养物中,用移液管将菌液接至液体培养基中,或从液体培养物中将菌液移至固体培养基中,都可称为液体接种。
7)注射接种该法是用注射的方法将待接的微生物转接至活的生物体内,如人或其它动物中,常见的疫苗预防接种,就是用注射接种,接入人体,来预防某些疾病。
8)活体接种活体接种是专门用于培养病毒或其它病原微生物的一种方法,因为病毒必须接种于活的生物体内才能生长繁殖。
所用的活体可以是整个动物;也可以是某个离体活组织,例如猴肾等;也可以是发育的鸡胚。
接种的方式是注射,也可以是拌料喂养。
2、无菌操作培养基经高压灭菌后,用经过灭菌的工具(如接种针和吸管等)在无菌条件下接种含菌材料(如样品、菌苔或菌悬液等)于培养基上,这个过程叫做无菌接种操作。
在实验室检验中的各种接种必须是无菌操作。
实验台面不论是什么材料,一律要求光滑、水平。
光滑是便于用消毒剂擦洗;水平是倒琼脂培养基时利于培养皿内平板的厚度保持一致。
在实验台上方,空气流动应缓慢,杂菌应尽量减少,其周围杂菌也应越少越好。
为此,必须清扫室内,关闭实验室的门窗,并用消毒剂进行空气消毒处理,尽可能地减少杂菌的数量。
空气中的杂菌在气流小的情况下,随着灰尘落下,所以接种时,打开培养皿的时间应尽量短。
用于接种的器具必须经干热或火焰等灭菌。
接种环的火焰灭菌方法:通常接种环在火焰上充分烧红(接种柄,一边转动一边慢慢地来回通过火焰三次),冷却,先接触一下培养基,待接种环冷却到室温后,方可用它来挑取含菌材料或菌体,迅速地接种到新的培养基上。
(图3-4)然后,将接种环从柄部至环端逐渐通过火焰灭菌,复原。
不要直接烧环,以免残留在接种环上的菌体爆溅而污染空间。
平板接种时,通常把平板的面倾斜,把培养皿的盖打开一小部分进行接种。
在向培养皿内倒培养基或接种时,试管口或瓶壁外面不要接触底皿边,试管或瓶口应倾斜一下在火焰上通过。
图3-4斜面接种时的无菌操作(1)接种灭菌(2)开启棉塞(3)管口灭菌(4)挑起菌苔(5)接种(6)塞好棉塞二、分离纯化含有一种以上的微生物培养物称为混和培养物(Mixed culture)。
如果在一个菌落中所有细胞均来自于一个亲代细胞,那么这个菌落称为纯培养(Pure culture)。
在进行菌种鉴定时,所用的微生物一般均要求为纯的培养物。
得到纯培养的过程称为分离纯化,方法有许多种。
1、倾注平板法首先把微生物悬液通过一系列稀释,取一定量的稀释液与熔化好的保持在40~50°左右的营养琼脂培养基充分混合,然后把这混合液倾注到无菌的培养皿中,待凝固之后,把这平板倒置在恒箱中培养。
单一细胞经过多次增殖后形成一个菌落,取单个菌落制成悬液,重复上述步骤数次,便可得到纯培养物。
(图3-5,a)图3-5倾注平板法(a)涂布平板法(b)图解1.菌悬液2.熔化的培养基3.培养物4.无菌水2、涂布平板法首先把微生物悬液通过适当的稀释,取一定量的稀释液放在无菌的已经凝固的营养琼脂平板上,然后用无菌的玻璃刮刀把稀释液均匀地涂布在培养基表面上,经恒温培养便可以得到单个菌落。
(图3-5,b)3、平板划线法最简单的分离微生物的方法是平板划线法。
用无菌的接种环取培养物少许在平板上进行划线。
划线的方法很多,常见的比较容易出现单个菌落的划线方法有斜线法、曲线法、方格法、放射法、四格法等。
(图3-6)当接种环在培养基表面上往后移动时,接种环上的菌液逐渐稀释,最后在所划的线上分散着单个细胞,经培养,每一个细胞长成一个菌落。
(图3-7)4、富集培养法富集培养法的方法和原理非常简单。
我们可以创造一些条件只让所需的微生物生长,在这些条件下,所需要的微生物能有效地与其他微生物进行竞争,在生长能力方面远远超过其他微生物。
所创造的条件包括选择最适的碳源、能源、温度、光、pH、渗透压和氢受体等。
在相同的培养基和培养条件下,经过多次重复移种,最后富集的菌株很容易在固体培养基上长出单菌落。
如果要分离一些专性寄生菌,就必须把样品接种到相应敏感宿主细胞群体中,使其大量生长。
通过多次重复移种便可以得到纯的寄生菌。
图3-6平板划线分离法1.斜线法2.曲线法3.方格法4.放射法5.四格法5、厌氧法在实验室中,为了分离某些厌氧菌,可以利用装有原培养基的试管作为培养容器,把这支试管放在沸水0浴中加热数分钟,以便逐出培养基中的溶解氧。
然后快速冷却,并进行接种。
接种后,加入无菌的石蜡于培养基表面,使培养基与空气隔绝。
另一种方法是,在接种后,利用N2或CO2取代培养基中的气体,然后在火焰上把试管口密封。
有时为了更有效地分离某些厌氧菌,可以把所分离的样品接种于培养基上,然后再把培养皿放在完全密封的厌氧培养装置中。
三、培养微生物的生长,除了受本身的遗传特性决定外,还受到许多外界因素的影响,如营养物浓度、温度、水分、氧气、PH等。
微生物的种类不同,培养的方式和条件也不尽相同。
1、影响微生物生长的因素微生物的生长,除了受本身的遗传特性决定外,还受到外界许多因素的影响。
影响微生物生长的因素很多,简要介绍如下。
1) 营养物浓度细菌的生长率与营养物的浓度有关:μ=μmax*C/(K+C)营养物浓度与生长率的关系曲线是典型的双曲线。
K值是细菌生长的很基本的特性常数。
它的数值很小,表明细菌所需要的营养浓度非常之低,所以在自然界中,它们到处生长。
然而营养太低时,细菌生长就会遇到困难,甚至还会死亡。
这是因为除了生长需要能量以外,细菌还需要能量来维持它的生存。
这种能量称为维持能。
另一方面,随着营养物浓度的增加,生长率愈接近最大值。
2)温度在一定的温度范围内,每种微生物都有自已的生长温度三基点:最低生长温度、最适生长温度和最高生长温度。
在生长温度三基点内,微生物都能生长,但生长速率不一样。
微生物只有处于最适生长温度时,生长速度才最快,代时最短。
超过最低生长温度,微生物不会生长,温度太低,甚至会死亡。
超过最高生长温度,微生物也要停止生长,温度过高。
也会死亡。
一般情况下,每种微生物的生长温度三基点是恒定的。
但也常受其它环境条件的影响而发生变化。
根据微生物最适生长温度的不同,可将它们分为三个类型:a.嗜冷微生物:其是适生长温度多数在-10℃-20℃之间b.中温微生物:其最适生长温度一般在20℃-45℃之间c.嗜热微生物:生长温度在45℃以上。
3)水分水分是微生物进行生长的必要条件。
芽孢、孢子萌发,首先需要水分。
微生物是不能脱离水而生存的。
但是微生物只能在水溶液中生长,而不能生活在纯水中。
各种微生物在不能生长发育的水分活性范围内,均具有狭小的适当的水分活性区域。
4)氧气按照微生物对氧气的需要情况,可将它们分为以下五个类型。
a.需氧微生物这类微生物需要氧气供呼吸之用。
没有氧气,便不能生长,但是高浓度的氧气对需氧微生物也是有毒的。
很多需氧微生物不能在氧气浓度大于大气中氧气浓度的条件下生长。
绝大多数微生物都属于这个类型。
b.兼性需氧微生物这类微生物在有氧气存在或无氧气存在情况下,都能生长,只不过所进行的代谢途径不同罢了。
在无氧气存在的条件下,它进行发酵作用,例如酵母菌的无氧乙醇发酵。
c.微量需氧微生物这类菌是需要氧气的,但只在0.2大气压下生长最好。
这可能是由一它们含有在强氧化条件下失活的酶,因而只有在低压下作用。
d.耐氧微生物这类微生物在生长过程中,不需要氧气,但也不怕氧气存在,不会被氧气所杀死。
c.厌氧微生物这类微生物在生长过程中,不需要分子氧。
分子氧存在对它们生长产生毒害,不是被抑制,就是被杀死。
2、培养方法1)根据培养时是否需要氧气,可分为好氧培养和厌氧培养两大类。
好氧培养:也称“好气培养”。
就是说这种微生物在培养时,需要有氧气加入,否则就不能生长良好。
在实验室中,斜面培养是通过棉花塞从外界获得无菌的空气。
三角烧瓶液体培养多数是通过摇床振荡,使外界的空气源源不断地进入瓶中。
厌氧培养:也称“厌气培养”。
这类微生物在培养时,不需要氧气参加。
在厌氧微生物的培养过程中,最重要的一点就是要除去培养基中的氧气。
一般可采用下列几种方法:a.降低培养基中的氧化还原电位:常将还原剂如谷胱甘肽、硫基醋酸盐等,加入到培养基中,便可达到目的。
有的将一些动物的死的或活的组织如牛心、羊脑加入到培养基中,也可适合厌氧菌的生长。
b.化合去氧:这也有很多方法,主要有:用焦性没食子酸吸收氧气;用磷吸收氧气;用好氧菌与厌氧混合培养吸收氧气;用植物组织如发芽的种子吸收氧气;用产生氢气与氧化合的方法除氧。
c.隔绝阻氧:深层液体培养;用石蜡油封存;半固体穿刺培养。
d.替代驱氧用二氧气碳驱代氧气;用氮气驱代氧气;用真空驱代氧气;用氢气驱代氧气;用混和气体驱代氧气。
2)根据培养基的物理状态,可分为固体培养和液体培养两大类。
固质培养:是将菌种接至疏松而富有营养的固体培养基中,在合适的条件下进行微生物培养的方法。
液体培养:在实验中,通过液体培养可以使微生物迅速繁殖,获得大量的培养物,在一定条件下,还是微生物选择增菌的有效方法。